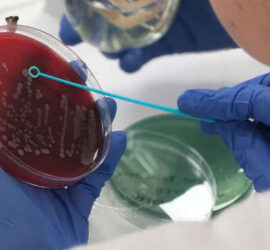

Calidad en el laboratorio
Capacitar al alumnado para detectar, reducir y corregir las posibles deficiencias en el laboratorio, antes de emitir un resultado. Son todos los mecanismos, acciones, herramientas que realizamos para detectar la presencia de errores. Dar a conocer buenas prácticas de higiene, normas analíticas, acreditaciones, circuitos de intercomparación… 6. INFORMACIÓN CALIDAD EN […]